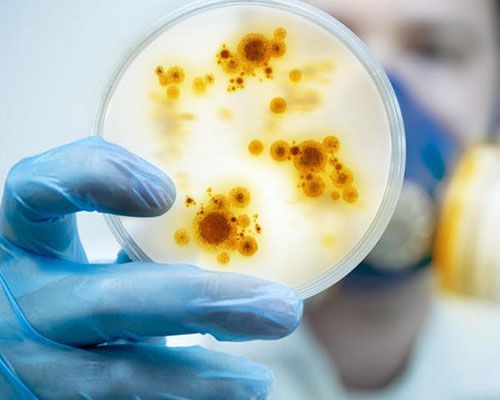
Disinfezione Virus, batteri e muffe

Operazioni di disinfestazione civile e industriale per aziende e privati
Tipologie di infestanti e rischi per gli ambienti
Elis Pest Control
si rivolge ad aziende e privati nel campo della disinfestazione civile e industriale. Grazie al costantemente aggiornato sulle varie tecniche d’intervento, può risolvere ogni tipo di problema creato da infestazioni d’insetti, scarafaggi, cimici e zecche con il minimo disagio per i clienti.
Quali rischi possono sorgere?
Igiene: gli infestanti veicolano numerosi germi e batteri patogeni.
Danni: gli infestanti rappresentano una minaccia per l'integrità degli edifici diretti ed indiretti.
Immagine: la presenza di infestanti può minacciare l'immagine del vostro marchio.
Ratto
I ratti rappresentano un rischio per i materiali e l'igiene nella tua azienda. Per combattere efficacemente questi roditori, i team di tecnici Elis mettono in atto azioni preventive. In caso di effettiva infestazione, effettuano interventi curativi per ridurre drasticamente il numero di roditori. Mettiamo a vostra disposizione team di tecnici dedicati alla lotta contro gli infestanti con una formazione specifica e sempre nel rispetto della normativa.
Topo
I topi possono causare incendi nei tuoi locali. Per combattere questo infestante, Elis ha messo a punto un sistema di protezione preventiva. In caso di infestazione gli esperti determinano gli interventi curativi da effettuare. Mettiamo a vostra disposizione team di tecnici dedicati alla lotta contro gli infestanti con una formazione specifica e sempre nel rispetto della normativa.
Ratto nero
I ratti rappresentano un rischio per i materiali e l'igiene nella tua azienda. Per combattere efficacemente i roditori, i nostri team di tecnici mettono in atto azioni preventive. In caso di effettiva infestazione, vengono effettuati interventi curativi per ridurre drasticamente il numero di roditori. Mettiamo a vostra disposizione team di tecnici dedicati alla lotta contro gli infestanti con una formazione specifica e sempre nel rispetto della normativa.
Cimice da letto
Questo parassita rappresenta un rischio per l'igiene e l'immagine della tua azienda. I team di Elis sono specializzati nel combattere questo problema. In caso di infestazione, effettuiamo un trattamento mirato tramite l’impiego di un insetticida efficace contro la resistenza delle cimici o trattamenti termici. La nostra modalità operativa molto rigorosa prevede 3 passaggi, con intervallo di 7 giorni tra ognuno, al fine di eliminare l'intera popolazione.
Pulce
Questo parassita rappresenta un rischio per l'igiene e l'immagine della tua azienda. I team di Elis sono specializzati nel combattere questo problema. In caso di infestazione, effettuano una diagnosi per stabilire un trattamento mirato. Eliminano l'intera popolazione nebulizzando un insetticida efficace contro la resistenza delle pulci.
Zanzara
Le zanzare possono portare malattie pericolose. Le loro punture sono molto fastidiose. Elis propone dei sistemi di protezione che agiscono sia a livello preventivo che curativo. Mettiamo in atto soluzioni adatte alle diverse fasi di sviluppo della zanzara al fine di bloccare il ciclo riproduttivo per un risultato più duraturo. I nostri esperti intervengono per effettuare una diagnosi dei tuoi locali al fine di determinare le strategie più efficaci.
Mosche e moscerini
Mosche e moscerini rappresentano un rischio per l'igiene e l'immagine della tua azienda. Elis propone sistemi per l'eliminazione di mosche e moscerini come misura preventiva e curativa. Le nostre soluzioni con lampade sono progettate per attirare e catturare in modo efficace e discreto gli insetti volanti. I nostri esperti sono a tua disposizione per consigliarti sulla posizione (strategica) e sull'installazione.
Tarme dei tessuti
Le tarme dei tessuti possono attaccare e rovinare irreversibilmente i tuoi abiti. Elis propone dei sistemi di protezione che agiscono sia a livello preventivo che curativo. Lontane dalla vista dei tuoi clienti, le trappole a feromoni, o sistemi di confusione sessuale, costituiscono un metodo di lotta preventivo ecoresponsabile, senza insetticidi. In caso di infestazione, i team di esperti eseguono azioni curative di nebulizzazione per un'efficienza ottimale. I nostri team dedicati alla disinfestazione sono in grado di determinare la modalità di trattamento più adatta al tuo ambiente.
Tignole della farina
Le tignole della farina possono distruggere i tuoi prodotti e minacciare l'igiene e l'immagine della tua azienda. Elis propone dei sistemi di protezione che agiscono sia a livello preventivo che curativo. Lontane dalla vista dei tuoi clienti, le trappole a feromoni costituiscono un metodo di lotta preventivo ecoresponsabile, senza insetticidi. In caso di infestazione, i nostri team di esperti svolgono azioni curative con prodotti nel rispetto delle normative.
Disinfezione Virus, batteri e muffe
I microrganismi nocivi rappresentano un rischio per la salute dei tuoi dipendenti e per l'igiene e l'immagine della tua azienda. Elis ti propone un servizio di disinfezione microbica innocuo per la salute umana. Permette un trattamento adeguato dei tuoi locali, in particolare quelli destinati alla preparazione di generi alimentari.
Vespa
Le punture di vespe possono rappresentare un vero pericolo per la salute. Elis propone dei sistemi di protezione che agiscono sia a livello preventivo che curativo contro questo parassita. In caso di presenza di nidi, i nostri tecnici utilizzano sistemi all'avanguardia per eliminarli senza alcun impatto sull'ambiente. I nostri esperti dispongono di dispositivi di protezione e di un protocollo rigoroso per eseguire il trattamento in sicurezza. Le nostre soluzioni di cattura preventiva ti offrono protezione e tranquillità. I nostri team ti aiutano ad installarli in posti strategici per ottimizzare la loro efficienza.
Calabrone
Le punture di calabrone possono essere molto pericolose e causare delle complicazioni. In caso di presenza di nidi, i nostri tecnici utilizzano sistemi all'avanguardia per eliminarli riducendo al minimo l'impatto sull'ambiente. I nostri esperti dispongono di dispositivi di protezione e di un protocollo rigoroso per eseguire il trattamento in sicurezza.
Formica
Le formiche possono influenzare l'igiene e l'immagine della tua azienda. Il servizio di disinfestazione di Elis combina un'azione curativa e un monitoraggio preventivo al fine di garantire una soluzione ottimale. I nostri esperti intervengono rapidamente in caso di infestazione per limitare il rischio di propagazione. Il successo dei nostri interventi è dovuto anche all'utilizzo di insetticidi ad effetto immediato per un trattamento contro le formiche efficace nel tempo. Invisibili agli occhi dei tuoi clienti, l'applicazione dei prodotti utilizzati garantisce una sicurezza ottimale nel pieno rispetto delle normative.
Servizio allontanamento volatili
Gli escrementi di questo animale portano a un degrado delle infrastrutture, influendo sull'igiene ma anche sull'immagine della tua azienda. Elis ti offre un servizio completo di allontanamento volatili con diversi sistemi di protezione. I nostri team di tecnici specializzati effettuano un'analisi della situazione per definire una soluzione adatta al tuo ambiente e in grado di soddisfare al meglio le tue esigenze.
Questo servizio è disponibile solo per alcune zone d’Italia.
Blatte
Le blatte rappresentano un rischio per la salute. Il servizio di disinfestazione di Elis combina un'azione curativa e un monitoraggio preventivo al fine di garantire una soluzione ottimale. I nostri esperti intervengono rapidamente in caso di infestazione per limitare il rischio di propagazione. Il successo dei nostri interventi è dovuto anche all'utilizzo di insetticidi ad effetto immediato, efficaci nel tempo. Invisibili agli occhi dei tuoi clienti, l'installazione dei prodotti utilizzati garantisce una sicurezza ottimale nel pieno rispetto delle normative.
Carabide
Il carabide è attivo di notte e si nutre di cereali, semi e frutti. Insetto stagionale, presente soprattutto in estate, va in letargo nel terreno ai primi freddi. Completamente innocuo, infastidisce con la sua presenza e danneggia l'immagine della tua azienda.
Se sei un'azienda contatta Elis Pest Control
Offriamo un servizio di intervento rapido e risolutivo per tutti i tipi di infestazione. Puoi sempre contare su di noi che, grazie ad attrezzature all'avanguardia e personale altamente qualificato, saremo in grado di risolvere rapidamente ogni problema di infestazione da roditori, zanzare, volatili, blatte ed altri tipi di insetti.
Richiedi subito il nostro servizio di
derattizzazione,
disinfestazione,
disinfezione,
sanificazione
ed
allontanamento volatili, garantiamo interventi altamente professionali e tempestivi.
Richiedi un sopralluogo
Tutti i campi sono obbligatori
Contattaci
Ti risponderemo il più presto possibile.
Riprova in un secondo momento.
SIAMO QUI PER ASCOLTARE I TUOI BISOGNI
Contattaci subito per richiedere un intervento dei nostri operatori per operazioni mirate per la disinfestazione da insetti, zanzare e larve.